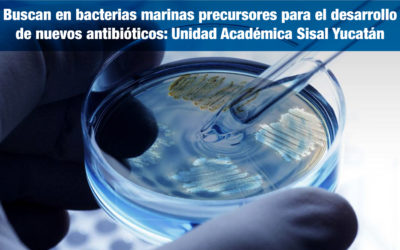
Buscan en bacterias marinas precursores para el desarrollo de nuevos antibióticos: Unidad Académica en Sisal, Yucatán

Investigadores de la Universidad Veracruzana y la UNAM desarrollan un sistema de detección temprana y precisa para cáncer de mama
Científicos pertenecientes al Instituto de Investigaciones Biológicas de la Universidad Veracruzana (UV) y del Instituto de Investigaciones Biomédicas de la Universidad Nacional Autónoma de México (UNAM), desarrollaron un proceso para la detección de cáncer de mama...
Un grupo de científicos trabaja en el desarrollo de un sistema de activación e inactivación lumínico para la administración precisa de fármacos contra dolores crónicos.
El pasado 11 de abril del presente año se publicaron en la revista eLife los resultados de un estudio realizado por un equipo de científicos españoles, franceses e italianos, que probaron con éxito la activación lumínica de analgésico, lo que a mediano plazo podría...
Investigan el uso de nano vesículas extracelulares programadas para la entrega de fármacos a tejidos específicos del organismo
A grandes rasgos podríamos decir que la biodisponibilidad de un fármaco es la cualidad para que la sal o el principio activo del mismo alcance (sin que su estructura farmacológica sea alterada o inhabilitada, y en un tiempo determinado “farmacocinética”) desde el...
Nuevo Programa de Estímulos Fiscales para impulsar la Investigación y Desarrollo de Tecnología en México y para México
El pasado 4 de abril, fue dado a conocer el Estímulo Fiscal a la Investigación y Desarrollo de Tecnología (EFIDT) en una presentación realizada en el recinto del Museo Numismático Nacional, en la que se contó con la participación del Dr. José Antonio Meade, titular de...
Buscan en bacterias marinas precursores para el desarrollo de nuevos antibióticos: Unidad Académica en Sisal, Yucatán
Dada la grave amenaza que representa para la humanidad el desarrollo progresivo de la resistencia de las bacterias frente a los antibióticos, hemos publicado en Código F diferentes artículos que abordan dicho tema. El 23 de enero de este año publicamos el artículo...
La mejor manera de ganarle la batalla a un tumor cancerígeno es ensayar previamente la cirugía
Hace relativamente poco tiempo, para ser precisos el 2 de febrero de este año, que de precisión es de lo hablaremos en este artículo, publicamos en Código F la sorprendente noticia de un grupo de científicos españoles que desarrollaron una bio-impresora 3D capaz de...